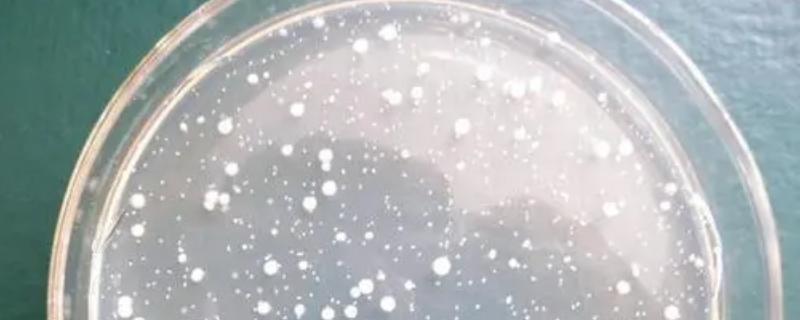
硝化细菌对鱼有害吗，硝化细菌的作用及使用方法

冬青怎么水养,冬青是树木还是花草

1、修剪枝条:准备生长健壮且无病虫害的冬青枝条,随后用剪刀修去底部的叶片,保留顶端的几片叶,底部则要呈斜口状。2、准备容器:首先对容器(透明容器)进行清洗消毒,随后把处理好的冬青枝条放进去,然后加入适量的水,以没过枝条1/3为宜,水位通常不能太高。3、日常养护:把冬青养护在通风好且温暖的地方,并在水浑浊后及时换水,通常可选用纯净水,若为自来水则要先晾晒后使用。需注意,可在换水时加入两滴营养液。
一、冬青怎么水养
1、修剪枝条
(1)准备生长正常、生长健壮、无病虫害的冬青枝条,随后对其合理的进行修剪。
(2)一般需要将底部的叶片剪掉,并将底部修剪成斜口,通常只需保留顶端的几片叶子,其目的在于避免叶子长期浸泡在水里后发生腐烂,污染水质。
2、准备容器
(1)建议选择透明的容器,其目的在于能更好的观察冬青的生长情况。
(2)把容器清洗干净并做好杀菌消毒工作,随后再把处理过的冬青枝条放入容器中,并加入适量的水,水位不宜太高,以没过枝条1/3为宜。需注意,一般可以使用纯净水,如果使用自来水的话,需要将其晾晒后再使用。
3、日常养护
(1)建议把冬青放在通风好、温暖的地方进行养护。
(2)待水浑浊后需要及时更换水,保证水质的干净。
(3)在每次换水的时候,一般可以往水里滴加两滴营养液。
二、冬青是树木还是花草
1、冬青属于花草还是树木
冬青一般是树木,它是无患子目、冬青科、冬青属的常绿乔木,拥有颜色为灰色或者淡灰色的树皮,淡绿色的小枝,其高度一般可达13m。
2、冬青对于生长环境的要求
(1)冬青适合生长在肥沃、湿润且排水良好的酸性土壤中。
(2)冬青是一个亚热带树种,喜欢温暖的气候。
(3)冬青具有比较耐阴湿、萌芽力强、耐修剪、对二氧化碳抗性强的特点,生于海拔为500-1000m的山坡常绿阔叶林中和林缘中。
(4)在栽种冬青的时候,既可以将它孤植在草坪上,也可以将它散植于叠石、小丘之上,同时对它进行矮化处理后,还能将它做成盆景观赏。